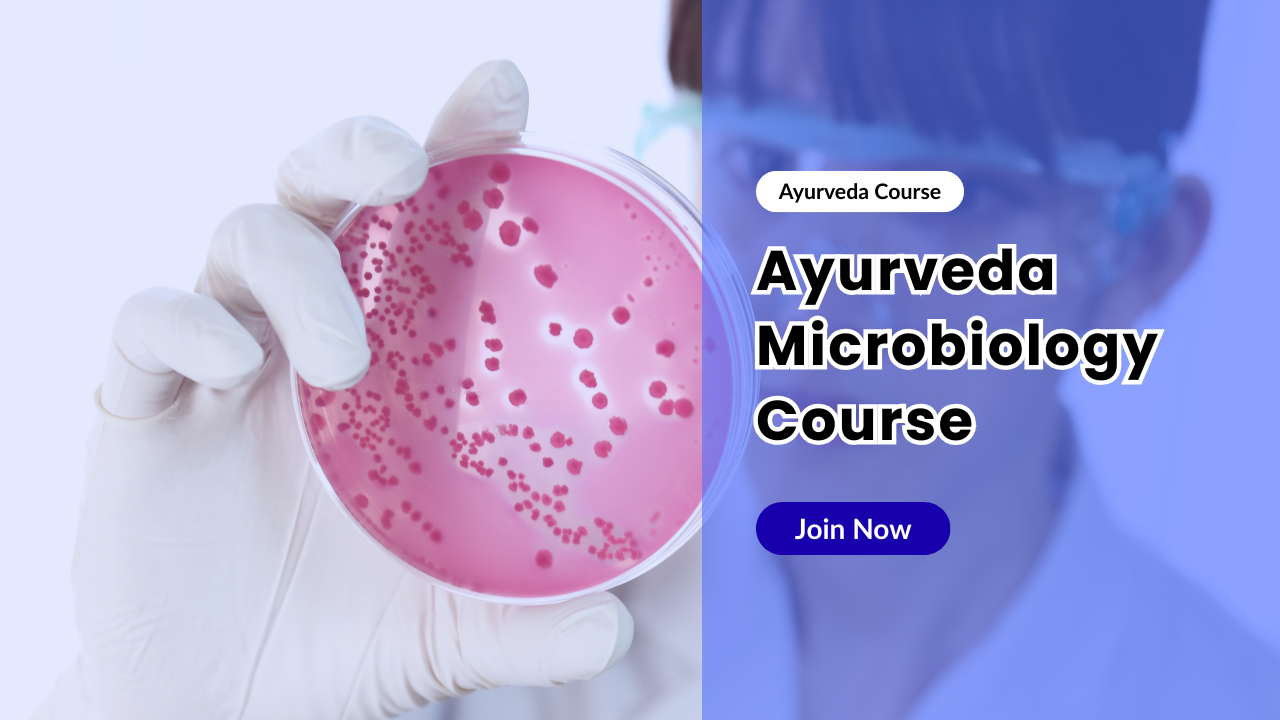
Microbiology course, ayurveda course,

Microbiology Ayurveda Course
- 1 Section
- 7 Lessons
- 3h 20m Duration
The Microbiology course covers a wide range of topics related to the study of microorganisms and their impact on various systems. It offers a detailed understanding of microbial life, including classification, growth, metabolism, genetics, and the role of microbes in diseases and environmental processes.
You must be logged in to submit a review .




